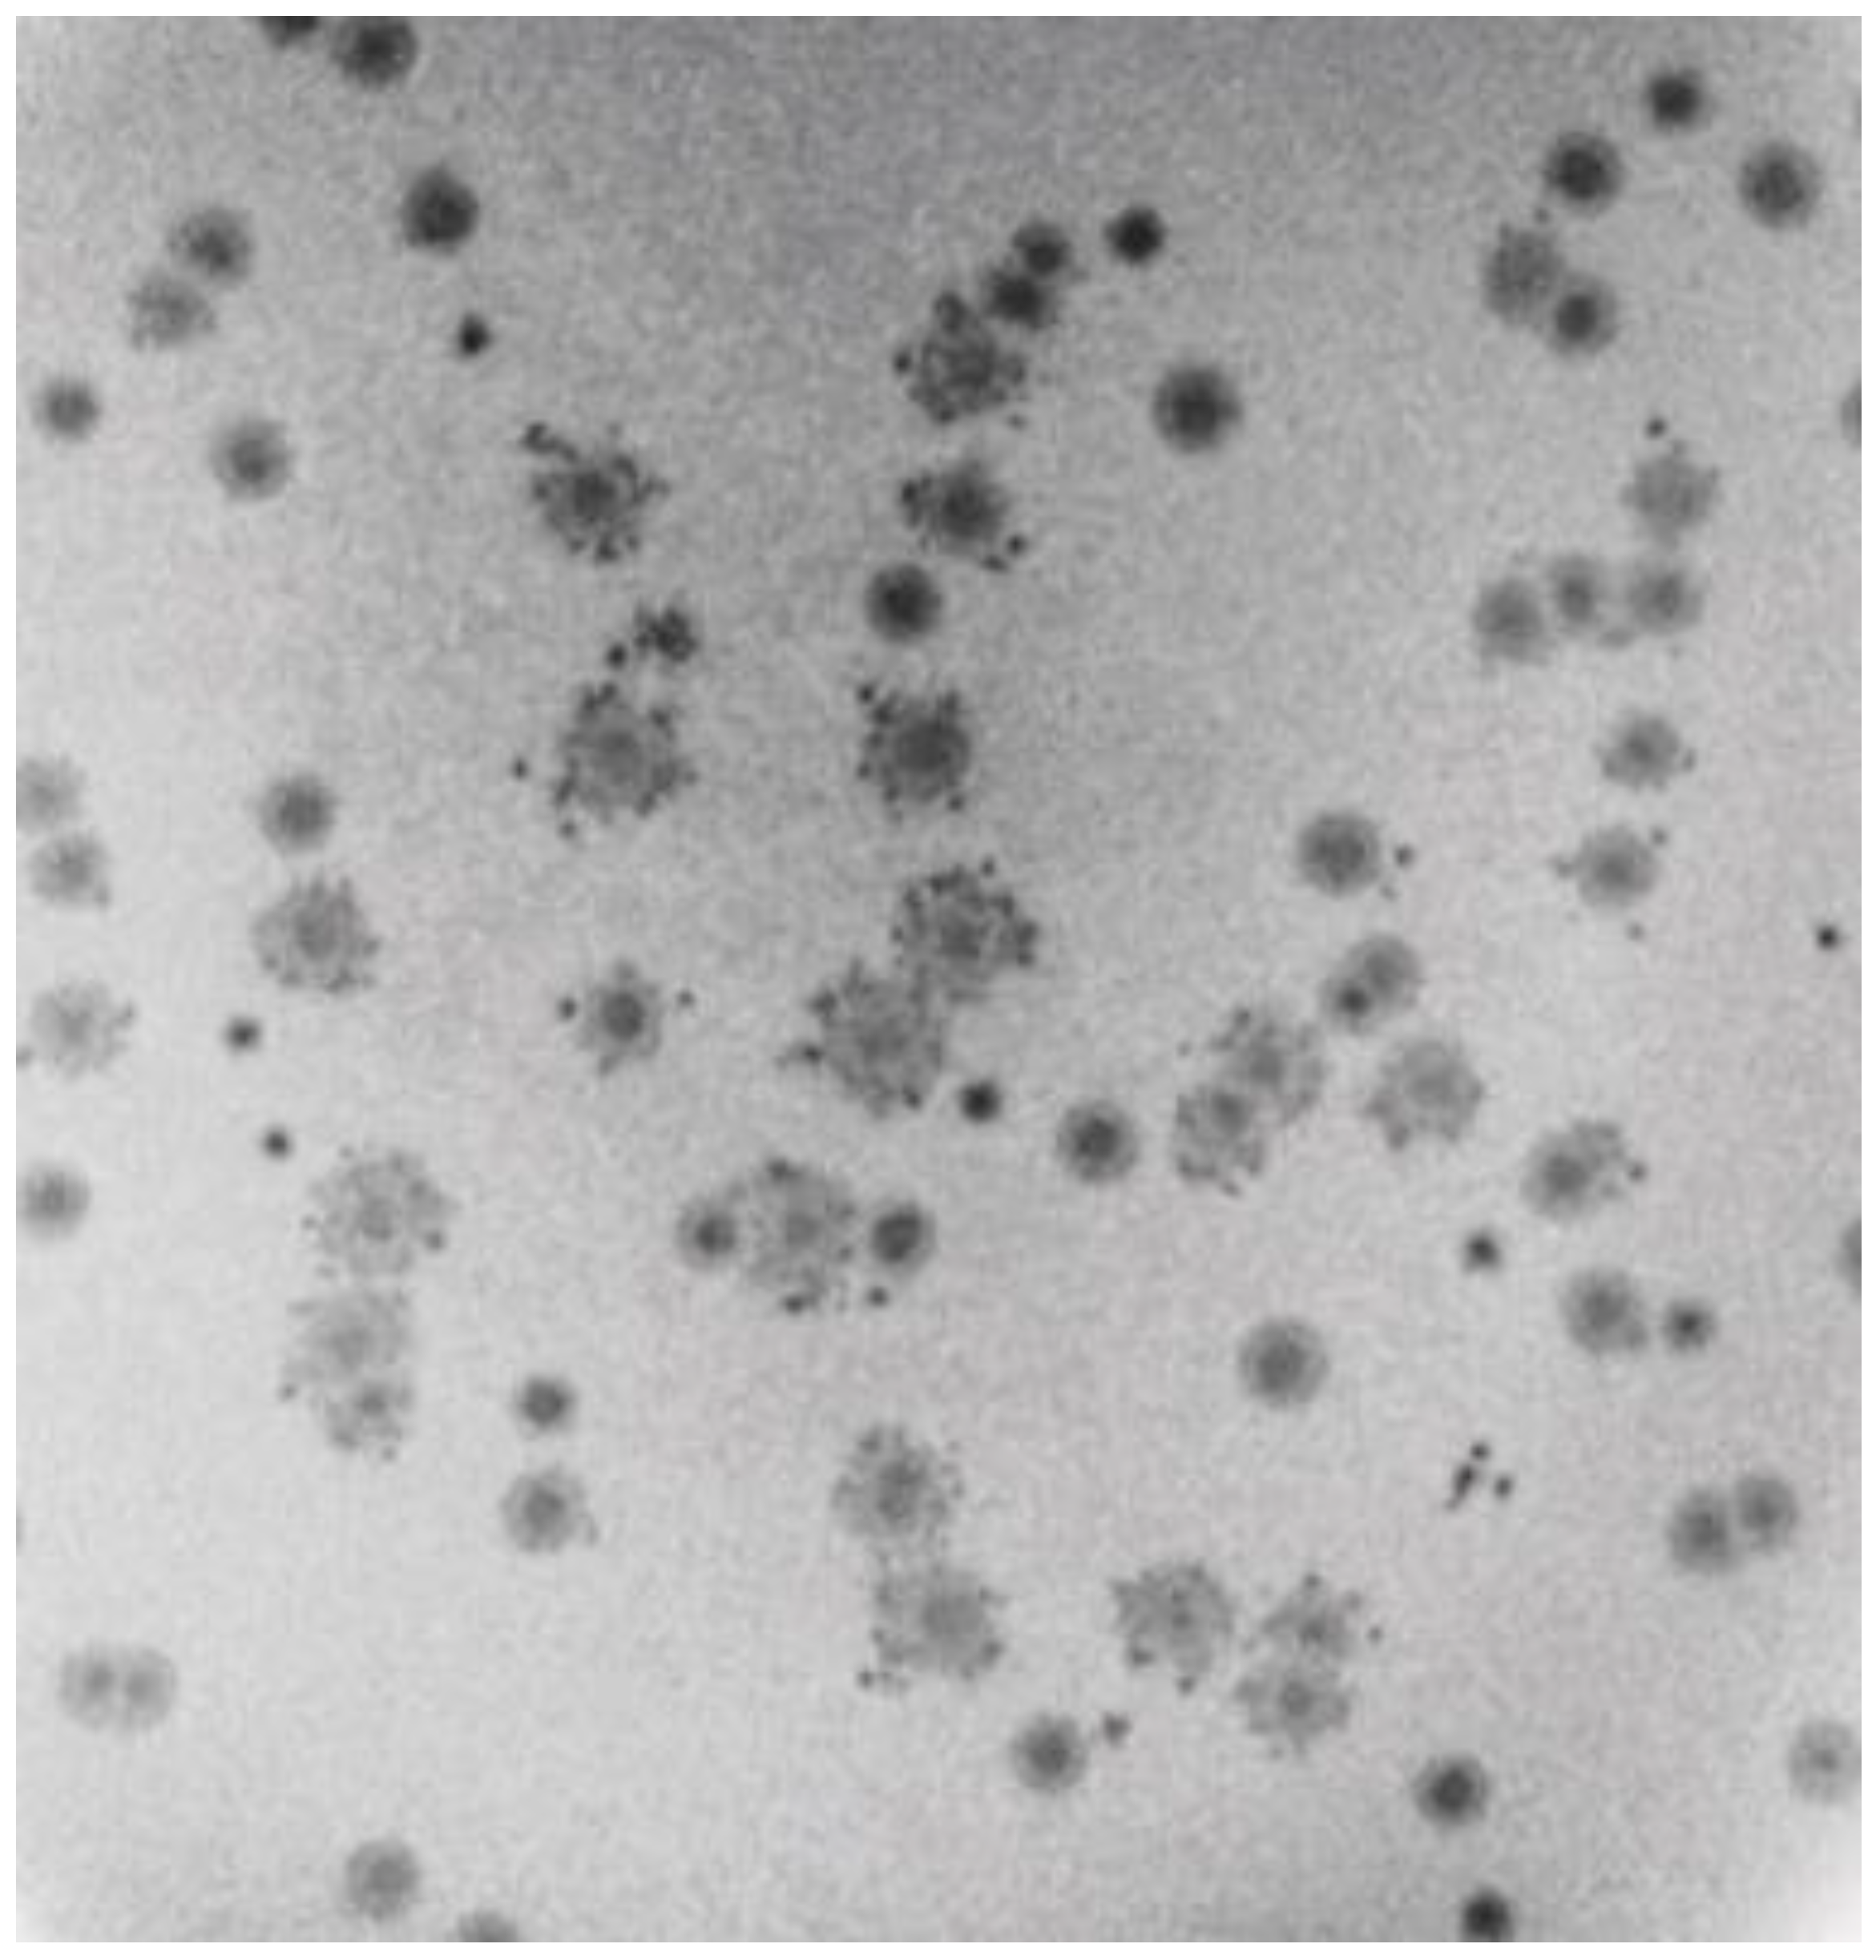

Siphophage 0105phi7-2 of Bacillus thuringiensis: Novel Propagation, DNA, and Genome-Implied Assembly
Abstract
1. Introduction
2. Results
2.1. Initial Screening and Characterization of Newly Isolated Phages
2.2. Rapid Rise in Plaque Diameter with Decreasing Plaque-Supporting Agarose Gel Percentage, A
2.3. Characteristics of 0105phi7-2 Plaques at Low A
2.4. Testing for Nonthermal Motion: Effects of Orthovanadate during Plaque Formation
2.5. Purification, DNA Sizing, and AGE
2.6. The Annotated Genome of 0105phi7-2: Proteins of the Mature Phage
2.7. Native Agarose Gel Electrophoresis, and Murine Persistence
3. Discussion
3.1. DN vs. A Plots: Explanation for the Change in Slope
3.2. Relationship of the Motion of Bacteria to the Formation of Large Plaques in 0105phi7-2
3.3. Bacterial Host and Conditions of Propagation
3.4. Physical and Chemical Phage Properties: Assembly
3.5. Genome: Orfans
3.6. Implications for Future Isolation of Phages
4. Materials and Methods
4.1. Propagation of Phages
4.2. Purification of Phages and Capsids
4.3. Native Agarose Gel Electrophoresis (AGE): Relative Values of Average Electrical Surface Charge Density (σ)
4.4. Determination of Persistence
4.5. Agarose Gel Electrophoresis of DNA
4.6. Electron Microscopy
4.7. Sequencing and Annotation of the 0105phi7-2 Genome
4.8. Mass Spectrometry Analysis of Capsid Proteins
Author Contributions
Funding
Institutional Review Board Statement
Informed Consent Statement
Data Availability Statement
Acknowledgments
Conflicts of Interest
References
- Delbrück, M. A physicist looks at biology. In Phage and the Origins of Molecular Biology; Cairns, J., Stent, G.S., Watson, J.D., Eds.; Cold Spring Harbor Laboratory Press: Cold Spring Harbor, NY, USA, 1966; pp. 9–22. [Google Scholar]
- Strauss, B.S. A physicist’s quest in biology: Max Delbrück and “complementarity”. Genetics 2017, 206, 641–650. [Google Scholar] [CrossRef] [PubMed]
- Susman, M. The Cold Spring Harbor Phage Course (1945–1970): A 50th anniversary remembrance. Genetics 1995, 139, 1101–1106. [Google Scholar] [CrossRef]
- Schrödinger, E. What Is Life? Mind and Matter; Cambridge University Press: Cambridge, UK, 1968. [Google Scholar]
- Rhoads, D.D.; Wolcott, R.D.; Kuskowski, M.A.; Wolcott, B.M.; Ward, L.S.; Sulakvelidze, A. Bacteriophage therapy of venous leg ulcers in humans: Results of a phase I safety trial. J. Wound Care 2009, 18, 237–243. [Google Scholar] [CrossRef] [PubMed]
- Kutter, E.; De Vos, D.; Gvasalia, G.; Alavidze, Z.; Gogokhia, L.; Kuhl, S.; Abedon, S.T. Phage Therapy in Clinical Practice: Treatment of Human Infections. Curr. Pharm. Biotechnol. 2010, 11, 69–86. [Google Scholar] [CrossRef] [PubMed]
- Danis-Wlodarczyk, K.; Dąbrowska, K.; Abedon, S.T. Phage Therapy: The Pharmacology of Antibacterial Viruses. Curr. Issues Mol. Biol. 2020, 40, 81–164. [Google Scholar] [CrossRef] [PubMed]
- Hibstu, Z.; Belew, H.; Akelew, Y.; Mengist, H.M. Phage Therapy: A Different Approach to Fight Bacterial Infections. Biol. Targets Ther. 2022, 16, 173–186. [Google Scholar] [CrossRef]
- Xu, H.-M.; Xu, W.-M.; Zhang, L. Current Status of Phage Therapy against Infectious Diseases and Potential Application beyond Infectious Diseases. Int. J. Clin. Pract. 2022, 2022, 4913146. [Google Scholar] [CrossRef]
- Hyman, P. Phages for Phage Therapy: Isolation, Characterization, and Host Range Breadth. Pharmaceuticals 2019, 12, 35. [Google Scholar] [CrossRef]
- Weber-Dąbrowska, B.; Jończyk-Matysiak, E.; Żaczek, M.; Łobocka, M.; Łusiak-Szelachowska, M.; Górski, A. Bacteriophage procurement for therapeutic purposes. Front. Microbiol. 2016, 7, 1177. [Google Scholar] [CrossRef]
- Alexyuk, P.; Bogoyavlenskiy, A.; Alexyuk, M.; Akanova, K.; Moldakhanov, Y.; Berezin, V. Isolation and characterization of lytic bacteriophages active against clinical strains of E. coli and development of a phage antimicrobial cocktail. Viruses 2022, 14, 2381. [Google Scholar] [CrossRef]
- Burrowes, B.H.; Molineux, I.J.; Fralick, J.A. Directed in Vitro Evolution of Therapeutic Bacteriophages: The Appelmans Protocol. Viruses 2019, 11, 241. [Google Scholar] [CrossRef]
- Mäntynen, S.; Sundberg, L.-R.; Oksanen, H.M.; Poranen, M.M. Half a Century of Research on Membrane-Containing Bacteriophages: Bringing New Concepts to Modern Virology. Viruses 2019, 11, 76. [Google Scholar] [CrossRef]
- Krammer, F.; Smith, G.J.D.; Fouchier, R.A.M.; Peiris, M.; Kedzierska, K.; Doherty, P.C.; Palese, P.; Shaw, M.L.; Treanor, J.; Webster, R.G.; et al. Influenza. Nat. Rev. Dis. Prim. 2018, 4, 3. [Google Scholar] [CrossRef]
- Yang, H.; Rao, Z. Structural biology of SARS-CoV-2 and implications for therapeutic development. Nat. Rev. Microbiol. 2021, 19, 685–700. [Google Scholar] [CrossRef]
- Serwer, P.; Hayes, S.J.; Zaman, S.; Lieman, K.; Rolando, M.; Hardies, S.C. Improved isolation of undersampled bacteriophages: Finding of distant terminase genes. Virology 2004, 329, 412–424. [Google Scholar] [CrossRef]
- Serwer, P.; Hayes, S.J.; Thomas, J.A.; Hardies, S.C. Propagating the missing bacteriophages: A large bacteriophage in a new class. Virol. J. 2007, 4, 21. [Google Scholar] [CrossRef]
- Hilt, E.E.; Ferrieri, P. Next Generation and Other Sequencing Technologies in Diagnostic Microbiology and Infectious Diseases. Genes 2022, 13, 1566. [Google Scholar] [CrossRef]
- Ben Khedher, M.; Ghedira, K.; Rolain, J.-M.; Ruimy, R.; Croce, O. Application and Challenge of 3rd Generation Sequencing for Clinical Bacterial Studies. Int. J. Mol. Sci. 2022, 23, 1395. [Google Scholar] [CrossRef]
- Serwer, P.; Hunter, B.; Wright, E.T. Electron Microscopy of In-Plaque Phage T3 Assembly: Proposed Analogs of Neurodegenerative Disease Triggers. Pharmaceuticals 2020, 13, 18. [Google Scholar] [CrossRef]
- Kauffman, K.M.; Hussain, F.A.; Yang, J.; Arevalo, P.; Brown, J.M.; Chang, W.K.; VanInsberghe, D.; Elsherbini, J.; Sharma, R.S.; Cutler, M.B.; et al. A major lineage of non-tailed dsDNA viruses as unrecognized killers of marine bacteria. Nature 2018, 554, 118–122. [Google Scholar] [CrossRef]
- Serwer, P.; Wright, E.T. In-Gel Isolation and Characterization of Large (and Other) Phages. Viruses 2020, 12, 410. [Google Scholar] [CrossRef] [PubMed]
- Chan, H.; Babayan, V.; Blyumin, E.; Gandhi, C.; Hak, K.; Harake, D.; Kumar, K.; Lee, P.; Li, T.T.; Liu, H.Y.; et al. The P-Type ATPase Superfamily. Microb. Physiol. 2010, 19, 5–104. [Google Scholar] [CrossRef] [PubMed]
- Kühlbrandt, W. Biology, structure and mechanism of P-type ATPases. Nat. Rev. Mol. Cell Biol. 2004, 5, 282–295. [Google Scholar] [CrossRef] [PubMed]
- Davidson, A.R.; Cardarelli, L.; Pell, L.G.; Radford, D.R.; Maxwell, K.L. Long Noncontractile Tail Machines of Bacteriophages. Adv. Exp. Med. Biol. 2012, 726, 115–142. [Google Scholar] [CrossRef] [PubMed]
- Montag, D.; Schwarz, H.; Henning, U. A component of the side tail fiber of Escherichia coli bacteriophage lambda can functionally replace the receptor-recognizing part of a long tail fiber protein of the unrelated bacteriophage T4. J. Bacteriol. 1989, 171, 4378–4384. [Google Scholar] [CrossRef]
- Stockdale, S.; Collins, B.; Spinelli, S.; Douillard, F.P.; Mahony, J.; Cambillau, C.; Van Sinderen, D. Structure and Assembly of TP901-1 Virion Unveiled by Mutagenesis. PLoS ONE 2015, 10, e0131676. [Google Scholar] [CrossRef]
- Bebeacua, C.; Lai, L.; Vegge, C.S.; Brøndsted, L.; van Heel, M.; Veesler, D.; Cambillau, C. Visualizing a Complete Siphoviridae Member by Single-Particle Electron Microscopy: The Structure of Lactococcal Phage TP901-1. J. Virol. 2013, 87, 1061–1068. [Google Scholar] [CrossRef]
- Orlov, I.; Roche, S.; Brasilès, S.; Lukoyanova, N.; Vaney, M.-C.; Tavares, P.; Orlova, E.V. CryoEM structure and assembly mechanism of a bacterial virus genome gatekeeper. Nat. Commun. 2022, 13, 7283. [Google Scholar] [CrossRef]
- Vegge, C.S.; Neve, H.; Brøndsted, L.; Heller, K.J.; Vogensen, F.K. Analysis of the Collar-Whisker Structure of Temperate Lactococcal Bacteriophage TP901-1. Appl. Environ. Microbiol. 2006, 72, 6815–6818. [Google Scholar] [CrossRef]
- Sun, M.; Serwer, P. The Conformation of DNA Packaged in Bacteriophage G. Biophys. J. 1997, 72, 958–963. [Google Scholar] [CrossRef]
- Prevelige, P.E.; Fane, B.A. Building the Machines: Scaffolding Protein Functions During Bacteriophage Morphogenesis. Adv. Exp. Med. Biol. 2012, 726, 325–350. [Google Scholar] [CrossRef]
- Duda, R.L.; Teschke, C.M. The amazing HK97 fold: Versatile results of modest differences. Curr. Opin. Virol. 2019, 36, 9–16. [Google Scholar] [CrossRef]
- Oh, B.; Moyer, C.L.; Hendrix, R.W.; Duda, R.L. The delt of the HK97 major capsid protein is essential for assembly. Virology 2014, 456–457, 171–178. [Google Scholar] [CrossRef]
- Huet, A.; Conway, J.F.; Letellier, L.; Boulanger, P. In Vitro Assembly of the T=13 Procapsid of Bacteriophage T5 with Its Scaffolding Domain. J. Virol. 2010, 84, 9350–9358. [Google Scholar] [CrossRef]
- Serwer, P.; Wright, E.T.; De La Chapa, J.; Gonzales, C.B. Basics for Improved Use of Phages for Therapy. Antibiotics 2021, 10, 723. [Google Scholar] [CrossRef]
- Fernandes, H.P.; Cesar, C.L.; Barjas-Castro, M.D.L. Electrical properties of the red blood cell membrane and immunohematological investigation. Rev. Bras. Hematol. Hemoter. 2011, 33, 297–301. [Google Scholar] [CrossRef]
- Jan, K.-M.; Chien, S. Role of Surface Electric Charge in Red Blood Cell Interactions. J. Gen. Physiol. 1973, 61, 638–654. [Google Scholar] [CrossRef]
- Choi, Y.; Bang, S.; Lee, H. Observation of Red Blood Cell Membrane Charge Using Magnetic Beads Under Pulsed Magnetic Field. IEEE Trans. Magn. 2022, 58, 5400105. [Google Scholar] [CrossRef]
- Serwer, P.; Wright, E.T. Gated Ethidium- and Bleomycin-Loading in Phage T4 That Is Subsequently Purified Leak-Free. Biophysica 2022, 2, 366–380. [Google Scholar] [CrossRef]
- Griess, G.A.; Moreno, E.T.; Easom, R.A.; Serwer, P. The sieving of spheres during agarose gel electrophoresis: Quantitation and modeling. Biopolymers 1989, 28, 1475–1484. [Google Scholar] [CrossRef]
- Dumais, M.; Kusukawa, N.; White, H. Highly Derivatized Agarose Conformational Nucleic Acid Separation. US Patent 5,641,626, 24 June 1997. [Google Scholar]
- Serwer, P.; Hunter, B.; Wright, E.T. Cell–gel interactions of in-gel propagating bacteria. BMC Res. Notes 2018, 11, 699. [Google Scholar] [CrossRef] [PubMed]
- Güler, S.; Oruç, Ç. Comparison of the behavior of negative electrically charged E. coli and E. faecalis bacteria under electric field effect. Colloids Surf. B Biointerfaces 2021, 208, 112097. [Google Scholar] [CrossRef] [PubMed]
- Bayer, M.E.; Sloyer, J.L., Jr. The electrophoretic mobility of Gram-negative and Gram-positive bacteria: An electrokinetic analysis. J. Gen. Microbiol. 1990, 136, 867–874. [Google Scholar] [CrossRef] [PubMed]
- Bond, M.C.; Vidakovic, L.; Singh, P.K.; Drescher, K.; Nadell, C.D. Matrix-trapped viruses can prevent invasion of bacterial biofilms by colonizing cells. eLife 2021, 10, e65355. [Google Scholar] [CrossRef] [PubMed]
- Winans, J.B.; Wucher, B.R.; Nadell, C.D. Multispecies biofilm architecture determines bacterial exposure to phages. PLoS Biol. 2022, 20, e3001913. [Google Scholar] [CrossRef]
- Chaban, Y.; Lurz, R.; Brasilès, S.; Cornilleau, C.; Karreman, M.; Zinn-Justin, S.; Tavares, P.; Orlova, E.V. Structural rearrangements in the phage head-to-tail interface during assembly and infection. Proc. Natl. Acad. Sci. USA 2015, 112, 7009–7014. [Google Scholar] [CrossRef]
- Seul, A.; Brasilès, S.; Petitpas, I.; Lurz, R.; Campanacci, V.; Cambillau, C.; Weise, F.; Zairi, M.; Tavares, P.; Auzat, I. Biogenesis of a Bacteriophage Long Non-Contractile Tail. J. Mol. Biol. 2021, 433, 167112. [Google Scholar] [CrossRef]
- Veesler, D.; Spinelli, S.; Mahony, J.; Lichière, J.; Blangy, S.; Bricogne, G.; Legrand, P.; Ortiz-Lombardia, M.; Campanacci, V.; van Sinderen, D.; et al. Structure of the phage TP901-1 1.8 MDa baseplate suggests an alternative host adhesion mechanism. Proc. Natl. Acad. Sci. USA 2012, 109, 8954–8958. [Google Scholar] [CrossRef]
- Guo, F.; Liu, Z.; Vago, F.; Ren, Y.; Wu, W.; Wright, E.T.; Serwer, P.; Jiang, W. Visualization of uncorrelated, tandem symmetry mismatches in the internal genome packaging apparatus of bacteriophage T7. Proc. Natl. Acad. Sci. USA 2013, 110, 6811–6816. [Google Scholar] [CrossRef]
- Poliakov, A.; Chang, J.R.; Spilman, M.S.; Damle, P.; Christie, G.E.; Mobley, J.; Dokland, T. Capsid Size Determination by Staphylococcus aureus Pathogenicity Island SaPI1 Involves Specific Incorporation of SaPI1 Proteins into Procapsids. J. Mol. Biol. 2008, 380, 465–475. [Google Scholar] [CrossRef]
- Chang, J.R.; Spilman, M.S.; Rodenburg, C.M.; Dokland, T. Functional domains of the bacteriophage P2 scaffolding protein: Identification of residues involved in assembly and protease activity. Virology 2009, 384, 144–150. [Google Scholar] [CrossRef]
- Gabashvili, I.S.; Khan, S.A.; Hayes, S.J.; Serwer, P. Polymorphism of bacteriophage T7. J. Mol. Biol. 1997, 273, 658–667. [Google Scholar] [CrossRef]
- Fremin, B.J.; Bhatt, A.S.; Kyrpides, N.C. Global phage small open reading frame (GP-SmORF) consortium. Thousands of small, novel genes predicted in global phage genomes. Cell. Rep. 2022, 39, 110984. [Google Scholar] [CrossRef]
- Al-Shayeb, B.; Sachdeva, R.; Chen, L.-X.; Ward, F.; Munk, P.; Devoto, A.; Castelle, C.J.; Olm, M.R.; Bouma-Gregson, K.; Amano, Y.; et al. Clades of huge phages from across Earth’s ecosystems. Nature 2020, 578, 425–431. [Google Scholar] [CrossRef]
- Hua, J.; Huet, A.; Lopez, C.A.; Toropova, K.; Pope, W.H.; Duda, R.L.; Hendrix, R.W.; Conway, J.F. Capsids and Genomes of Jumbo-Sized Bacteriophages Reveal the Evolutionary Reach of the HK97 Fold. mBio 2017, 8, e01579-17. [Google Scholar] [CrossRef]
- Donelli, G. Isolamento di un batteriofago di eccezionali dimensioni attivo su B. Megaterium. Cl. Sci. Fis. Mat. Nat. 1969, 44, 95–97. [Google Scholar]
- Serwer, P.; Hayes, S.J.; Thomas, J.A.; Demeler, B.; Hardies, S.C. Isolation of large and aggregating bacteriophages. Meth. Mol. Biol. 2009, 1, 55–66. [Google Scholar]
- Serwer, P.; Wright, E.T.; Liu, Z.; Jiang, W. Length quantization of DNA partially expelled from heads of a bacteriophage T3 mutant. Virology 2014, 456–457, 157–170. [Google Scholar] [CrossRef]
- Serwer, P. Gels for the propagation of bacteriophages and the characterization of bacteriophage assembly intermediates. In Bacteriophages; Kurtboke, I., Ed.; InTechOpen: London, UK, 2012; Available online: https://www.intechopen.com/books/bacteriophages/gels-for-the-propagation-of-bacteriophages-and-the-characterization-of-bacteriophage-assembly-interm (accessed on 3 March 2023).
- Fang, P.-A.; Wright, E.T.; Weintraub, S.T.; Hakala, K.; Wu, W.; Serwer, P.; Jiang, W. Visualization of Bacteriophage T3 Capsids with DNA Incompletely Packaged In Vivo. J. Mol. Biol. 2008, 384, 1384–1399. [Google Scholar] [CrossRef]
- Robinson, L.H.; Landy, A. HindII, HindIII, and HpaI restriction fragment maps of bacteriophage lambda DNA. Gene 1977, 2, 1–31. [Google Scholar] [CrossRef]
- Pajunen, M.I.; Elizondo, M.R.; Skurnik, M.; Kieleczawa, J.; Molineux, I.J. Complete Nucleotide Sequence and Likely Recombinatorial Origin of Bacteriophage T3. J. Mol. Biol. 2002, 319, 1115–1132. [Google Scholar] [CrossRef] [PubMed]
- Wang, J.; Jiang, Y.; Vincent, M.; Sun, Y.; Yu, H.; Wang, J.; Bao, Q.; Kong, H.; Hu, S. Complete genome sequence of bacteriophage T5. Virology 2005, 332, 45–65. [Google Scholar] [CrossRef] [PubMed]
- Lukashin, A.; Borodovsky, M. GeneMark.hmm: New solutions for gene finding. Nucleic Acids Res. 1998, 26, 1107–1115. [Google Scholar] [CrossRef] [PubMed]
- Altschul, S.F.; Madden, T.L.; Schäffer, A.A.; Zhang, J.; Zhang, Z.; Miller, W.; Lipman, D.J. Gapped BLAST and PSI-BLAST: A new generation of protein database search programs. Nucleic Acids Res. 1997, 25, 3389–3402. [Google Scholar] [CrossRef]
- Zimmermann, L.; Stephens, A.; Nam, S.-Z.; Rau, D.; Kübler, J.; Lozajic, M.; Gabler, F.; Söding, J.; Lupas, A.N.; Alva, V. A Completely Reimplemented MPI Bioinformatics Toolkit with a New HHpred Server at its Core. J. Mol. Biol. 2018, 430, 2237–2243. [Google Scholar] [CrossRef]
- Hardies, S.C.; Thomas, J.A.; Serwer, P. Comparative genomics of Bacillus thuringiensis phage 0305ϕ8-36: Defining patterns of descent in a novel ancient phage lineage. Virol. J. 2007, 4, 97. [Google Scholar] [CrossRef]

Disclaimer/Publisher’s Note: The statements, opinions and data contained in all publications are solely those of the individual author(s) and contributor(s) and not of MDPI and/or the editor(s). MDPI and/or the editor(s) disclaim responsibility for any injury to people or property resulting from any ideas, methods, instructions or products referred to in the content. |
© 2023 by the authors. Licensee MDPI, Basel, Switzerland. This article is an open access article distributed under the terms and conditions of the Creative Commons Attribution (CC BY) license (https://creativecommons.org/licenses/by/4.0/).
Share and Cite
Roberts, S.M.; Aldis, M.; Wright, E.T.; Gonzales, C.B.; Lai, Z.; Weintraub, S.T.; Hardies, S.C.; Serwer, P. Siphophage 0105phi7-2 of Bacillus thuringiensis: Novel Propagation, DNA, and Genome-Implied Assembly. Int. J. Mol. Sci. 2023, 24, 8941. https://doi.org/10.3390/ijms24108941
Roberts SM, Aldis M, Wright ET, Gonzales CB, Lai Z, Weintraub ST, Hardies SC, Serwer P. Siphophage 0105phi7-2 of Bacillus thuringiensis: Novel Propagation, DNA, and Genome-Implied Assembly. International Journal of Molecular Sciences. 2023; 24(10):8941. https://doi.org/10.3390/ijms24108941
Chicago/Turabian StyleRoberts, Samantha M., Miranda Aldis, Elena T. Wright, Cara B. Gonzales, Zhao Lai, Susan T. Weintraub, Stephen C. Hardies, and Philip Serwer. 2023. "Siphophage 0105phi7-2 of Bacillus thuringiensis: Novel Propagation, DNA, and Genome-Implied Assembly" International Journal of Molecular Sciences 24, no. 10: 8941. https://doi.org/10.3390/ijms24108941
APA StyleRoberts, S. M., Aldis, M., Wright, E. T., Gonzales, C. B., Lai, Z., Weintraub, S. T., Hardies, S. C., & Serwer, P. (2023). Siphophage 0105phi7-2 of Bacillus thuringiensis: Novel Propagation, DNA, and Genome-Implied Assembly. International Journal of Molecular Sciences, 24(10), 8941. https://doi.org/10.3390/ijms24108941

